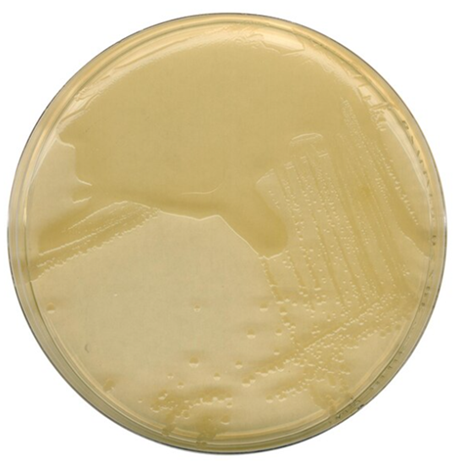
LB琼脂

LB琼脂供应商 更多
Sigma-Aldrich西格玛奥德里奇(上海)贸易有限公司
联系电话:021-61415566 800-8193336
产品介绍:
中文名称:LB 琼脂
英文名称:LB Agar
纯度:Vetec(TM) reagent grade
包装信息:250G
备注:V900857-250G
上海腾骞生物科技有限公司
联系电话:021-50895067 18616507272
产品介绍:
中文名称:LB琼脂
英文名称:LB AGAR, MILLER MODIFICATION
纯度:>98%
包装信息:500mg,1g,5g,10g,100g
备注:培养基
上海康朗生物科技有限公司
联系电话:021-61998208 18217752821
产品介绍:
中文名称:LB琼脂
英文名称:LB Agar
纯度:BR
包装信息:250g/200
备注:品牌:康朗生物/KALANG;其它纯度及规格报价请电询。
上海鼎芬化学科技有限公司
联系电话:021-57450129 17701764569
产品介绍:
中文名称:LB琼脂
英文名称:LB Agar
CAS:012111-18-4
纯度:BR
包装信息:1G,5G,25G,100G,500G
LB琼脂生产厂家及价格列表
LB琼脂
上海康朗生物科技有限公司
2026-04-03